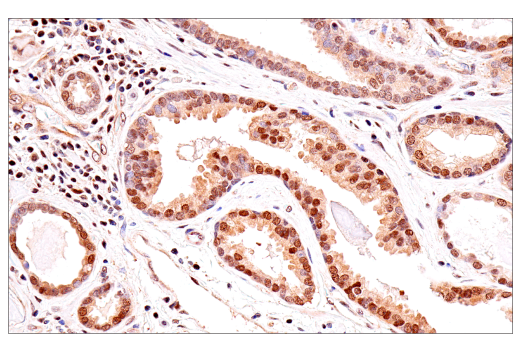
undefined Image 20: Phospho-Tau (Ser214/T217) Signaling Antibody Sampler Kit

Revision 2
#89892
Store at -20C
Phospho-Tau (Ser214/T217) Signaling Antibody Sampler Kit
1 Kit
(8 x 20 microliters)
877-616-CELL (2355)
877-678-TECH (8324)
3 Trask Lane | Danvers | Massachusetts | 01923 | USA
For Research Use Only. Not for Use in Diagnostic Procedures.
| Product Includes | Product # | Quantity | Mol. Wt | Isotype/Source |
|---|---|---|---|---|
| Tau (D1M9X) Rabbit Monoclonal Antibody | 46687 | 20 µl | 50-80 kDa | Rabbit IgG |
| Phospho-Tau (Ser214) (D1Q2X) Rabbit Monoclonal Antibody | 77348 | 20 µl | 50-80 kDa | Rabbit IgG |
| Phospho-Tau (Thr217) (E9Y4S) Rabbit Monoclonal Antibody | 51625 | 20 µl | 50-80 kDa | Rabbit IgG |
| Phospho-p38 MAPK (Thr180/Tyr182) (D3F9) Rabbit Monoclonal Antibody | 4511 | 20 µl | 43 kDa | Rabbit IgG |
| Phospho-SAPK/JNK (Thr183/Tyr185) (81E11) Rabbit Monoclonal Antibody | 4668 | 20 µl | 46, 54 kDa | Rabbit IgG |
| Phospho-p70 S6 Kinase (Thr389) (D5U1O) Rabbit Monoclonal Antibody | 97596 | 20 µl | 70, 85 kDa | Rabbit IgG |
| p38 MAPK (D13E1) Rabbit Monoclonal Antibody | 8690 | 20 µl | 40 kDa | Rabbit IgG |
| p70 S6 Kinase (E8K6T) Rabbit Monoclonal Antibody | 34475 | 20 µl | 70, 85 kDa | Rabbit IgG |
| Anti-rabbit IgG, HRP-linked Antibody | 7074 | 100 µl | Goat |
Please visit cellsignal.com for individual component applications, species cross-reactivity, dilutions, protocols, and additional product information.
Description
Storage
Background
Numerous kinases, including p38 MAPK, JNK, CDK5, GSK3β, and SGK1, have been shown to phosphorylate tau at Ser214, which is found in AD and dementia with Lewy bodies (4-9). p38 MAPK participates in a signaling cascade controlling cellular responses to cytokines and stress and is activated by phosphorylation at Thr180 and Tyr182, allowing for downstream tau Ser214 phosphorylation (10-13). Another kinase that phosphorylates the Ser214 site on tau is the stress-activated protein kinase/Jun-amino-terminal kinase (SAPK/JNK). SAPK/JNK is preferentially activated by a variety of environmental stresses, including UV and gamma radiation, ceramides, inflammatory cytokines, and, in some instances, growth factors and GPCR agonists, which lead to phosphorylation of Thr183 and Tyr185 (14-19).
Tau phosphorylation at Thr217 has been identified as a highly specific biomarker of AD. Phosphorylated tau at Thr217 can be detected in cerebrospinal fluid in both preclinical and advanced stages of AD and has been shown to successfully differentiate between AD and non-AD neurodegenerative diseases (20,21). One kinase identified to phosphorylate the Thr217 site on tau is p70 S6 kinase (S6K1). S6K1 is a mitogen activated Ser/Thr protein kinase that is required for cell growth and G1 cell cycle progression (22,23). Phosphorylation of Thr389 most closely correlates with S6K1 activity in vivo (24).
Background References
- Johnson, G.V. and Stoothoff, W.H. (2004) J Cell Sci 117, 5721-9.
- Hanger, D.P. et al. (1998) J Neurochem 71, 2465-76.
- Bramblett, G.T. et al. (1993) Neuron 10, 1089-99.
- Illenberger, S. et al. (1998) Mol Biol Cell 9, 1495-512.
- Götz, J. et al. (2001) Science 293, 1491-5.
- Yang, Y.C. et al. (2006) Mol Cell Biol 26, 8357-70.
- Liu, F. et al. (2006) FEBS Lett 580, 6269-74.
- Zhu, B. et al. (2010) Am J Physiol Lung Cell Mol Physiol 299, L493-501.
- Duka, V. et al. (2013) PLoS One 8, e75025.
- Rouse, J. et al. (1994) Cell 78, 1027-37.
- Han, J. et al. (1994) Science 265, 808-11.
- Lee, J.C. et al. Nature 372, 739-46.
- Freshney, N.W. et al. (1994) Cell 78, 1039-49.
- Davis, R.J. (1999) Biochem Soc Symp 64, 1-12.
- Ichijo, H. (1999) Oncogene 18, 6087-93.
- Kyriakis, J.M. and Avruch, J. (2001) Physiol Rev 81, 807-69.
- Kyriakis, J.M. (1999) J Biol Chem 274, 5259-62.
- Leppä, S. and Bohmann, D. (1999) Oncogene 18, 6158-62.
- Whitmarsh, A.J. and Davis, R.J. (1998) Trends Biochem Sci 23, 481-5.
- Barthélemy, N.R. et al. (2020) Alzheimers Res Ther 12, 26.
- Janelidze, S. et al. (2020) Nat Commun 11, 1683.
- Pullen, N. and Thomas, G. (1997) FEBS Lett 410, 78-82.
- Dufner, A. and Thomas, G. (1999) Exp Cell Res 253, 100-9.
- Weng, Q.P. et al. (1998) J Biol Chem 273, 16621-9.
Trademarks and Patents
Cell Signaling Technology is a trademark of Cell Signaling Technology, Inc.
All other trademarks are the property of their respective owners. Visit cellsignal.com/trademarks for more information.
Limited Uses
Except as otherwise expressly agreed in a writing signed by a legally authorized representative of CST, the following terms apply to Products provided by CST, its affiliates or its distributors. Any Customer's terms and conditions that are in addition to, or different from, those contained herein, unless separately accepted in writing by a legally authorized representative of CST, are rejected and are of no force or effect.
Products are labeled with For Research Use Only or a similar labeling statement and have not been approved, cleared, or licensed by the FDA or other regulatory foreign or domestic entity, for any purpose. Customer shall not use any Product for any diagnostic or therapeutic purpose, or otherwise in any manner that conflicts with its labeling statement. Products sold or licensed by CST are provided for Customer as the end-user and solely for research and development uses. Any use of Product for diagnostic, prophylactic or therapeutic purposes, or any purchase of Product for resale (alone or as a component) or other commercial purpose, requires a separate license from CST. Customer shall (a) not sell, license, loan, donate or otherwise transfer or make available any Product to any third party, whether alone or in combination with other materials, or use the Products to manufacture any commercial products, (b) not copy, modify, reverse engineer, decompile, disassemble or otherwise attempt to discover the underlying structure or technology of the Products, or use the Products for the purpose of developing any products or services that would compete with CST products or services, (c) not alter or remove from the Products any trademarks, trade names, logos, patent or copyright notices or markings, (d) use the Products solely in accordance with CST Product Terms of Sale and any applicable documentation, and (e) comply with any license, terms of service or similar agreement with respect to any third party products or services used by Customer in connection with the Products.
Revision 2



Revision 2



Revision 2



Revision 2



Revision 2



Revision 2

Revision 2



Revision 2



Revision 2



Revision 2



Revision 2



Revision 2



Revision 2



Revision 2



Revision 2



Revision 2



Revision 2



Revision 2



Revision 2



Revision 2
